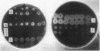
638

Abstract
An endo-1,4-beta-glucanase (EgI) gene isolated from Ruminococcus albus was deleted at the 5'-flanking region by gene truncation or at the 3'-flanking region by insertion of an omega (omega) fragment with a universal stop codon at the EcoRI or BamHI site. These modified genes were integrated into pUC vectors to construct chimera plasmids for Escherichia coli. The truncated EgIs were produced from transformants (E. coli) harboring the chimera plasmids. An EgI with a 15-amino-acid N-terminal deletion exibited higher activity at lower pH and temperature compared with the activity of the original EgI. The EgIs with 59- and 75-amino-acid deletions from the N and C terminals, respectively, had no activity, indicating that both terminal moieties are essential for enzyme activity.
Full text
PDF





Images in this article
Selected References
These references are in PubMed. This may not be the complete list of references from this article.
- Henikoff S. Unidirectional digestion with exonuclease III creates targeted breakpoints for DNA sequencing. Gene. 1984 Jun;28(3):351–359. doi: 10.1016/0378-1119(84)90153-7. [DOI] [PubMed] [Google Scholar]
- Ohmiya K., Kajino T., Kato A., Shimizu S. Structure of a Ruminococcus albus endo-1,4-beta-glucanase gene. J Bacteriol. 1989 Dec;171(12):6771–6775. doi: 10.1128/jb.171.12.6771-6775.1989. [DOI] [PMC free article] [PubMed] [Google Scholar]
- Ohmiya K., Nagashima K., Kajino T., Goto E., Tsukada A., Shimizu S. Cloning of the cellulase gene from Ruminococcus albus and its expression in Escherichia coli. Appl Environ Microbiol. 1988 Jun;54(6):1511–1515. doi: 10.1128/aem.54.6.1511-1515.1988. [DOI] [PMC free article] [PubMed] [Google Scholar]
- Ohmiya K., Shimizu M., Taya M., Shimizu S. Purification and properties of cellobiosidase from Ruminococcus albus. J Bacteriol. 1982 Apr;150(1):407–409. doi: 10.1128/jb.150.1.407-409.1982. [DOI] [PMC free article] [PubMed] [Google Scholar]
- Ohmiya K., Shirai M., Kurachi Y., Shimizu S. Isolation and properties of beta-glucosidase from Ruminococcus albus. J Bacteriol. 1985 Jan;161(1):432–434. doi: 10.1128/jb.161.1.432-434.1985. [DOI] [PMC free article] [PubMed] [Google Scholar]
- Prentki P., Krisch H. M. In vitro insertional mutagenesis with a selectable DNA fragment. Gene. 1984 Sep;29(3):303–313. doi: 10.1016/0378-1119(84)90059-3. [DOI] [PubMed] [Google Scholar]
- Ståhlberg J., Johansson G., Pettersson G. A binding-site-deficient, catalytically active, core protein of endoglucanase III from the culture filtrate of Trichoderma reesei. Eur J Biochem. 1988 Apr 5;173(1):179–183. doi: 10.1111/j.1432-1033.1988.tb13982.x. [DOI] [PubMed] [Google Scholar]
- Tomme P., Van Tilbeurgh H., Pettersson G., Van Damme J., Vandekerckhove J., Knowles J., Teeri T., Claeyssens M. Studies of the cellulolytic system of Trichoderma reesei QM 9414. Analysis of domain function in two cellobiohydrolases by limited proteolysis. Eur J Biochem. 1988 Jan 4;170(3):575–581. doi: 10.1111/j.1432-1033.1988.tb13736.x. [DOI] [PubMed] [Google Scholar]